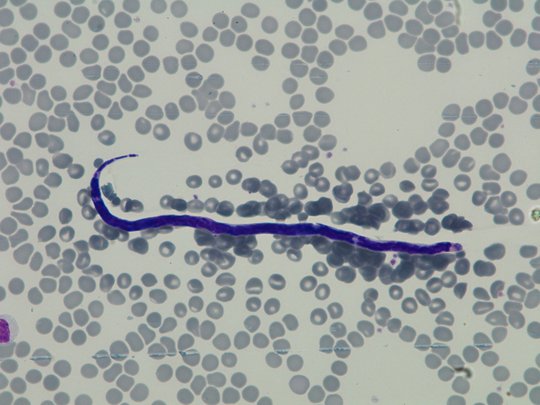
Das Foto zeigt einen lila Loa loa-Wurm (Blutausstrich nach Giemsa gefärbt 1:400).

Memento Forschungspreis 2024 für Hamburger Tropenmediziner
Das Memento-Bündnis würdigt das Engagement von Prof. Michael Ramharter von BNITM und UKE zur Bekämpfung des afrikanischen Augenwurms
Prof. Michael Ramharter vom Bernhard Nocht Institut für Tropenmedizin in Hamburg und dem Universitätsklinikum Hamburg-Eppendorf hat den Memento Forschungspreis 2024 erhalten. Die Auszeichnung würdigt seine langjährige Forschung zur Tropenkrankheit Loiasis, die der Augenwurm Loa loa verursacht. Die feierliche Verleihung fand im Berliner Medizinhistorischen Museum der Charité statt.

Loiasis ist eine durch den Wurm Loa loa verursachte Infektionskrankheit, die in ländlichen und oft schwer zugänglichen Wald- und Savannengebieten West- und Zentralafrikas auftritt. Der Wurm wird durch Bremsenbisse übertragen und kann sich im Körper des Menschen über Jahre hinweg bewegen, manchmal bis in das Auge, was dem Parasiten den Namen „Augenwurm“ gegeben hat. Betroffene leiden häufig an andauernden Kopfschmerzen, Gliederschmerzen und starkem Juckreiz. Die Krankheitslast ist enorm. Dennoch fehlt Loiasis bislang auf der Liste der Vernachlässigten Tropenkrankheiten (NTD) der Weltgesundheitsorganisation (WHO).
Seit mehr als zehn Jahren erforscht Prof. Ramharter gemeinsam mit Kolleg:innen aus Hamburg und Gabun die vernachlässigte Infektionskrankheit und ihre Auswirkungen. Die Wissenschaftlerinnen und Wissenschaftler arbeiten intensiv an der Entwicklung neuer Medikamente, da die bisher verfügbaren Mittel nicht nur veraltet, sondern auch mit schweren Nebenwirkungen behaftet sind. Neben der Entwicklung sicherer und wirksamerer Therapien strebt die Forschungsgruppe an, das Bewusstsein für Loiasis und deren Belastung für die ländliche Bevölkerung in Afrika südlich der Sahara zu stärken. Das Team schätzt, dass etwa 23,6 Millionen Patient:innen chronisch – oft lebenslang – mit Loa loa infiziert sind.
Der Preisjury zufolge hat Michael Ramharter während seiner langjährigen und intensiven Forschung zur Loiasis nicht nur das Verständnis dieser vernachlässigten Tropenkrankheit maßgeblich erweitert. Er habe auch neue Wege für Prävention, Diagnose und Behandlung eröffnet. Prof. Klaus Brehm betonte in seiner Laudatio Ramharters außergewöhnliches Engagement für die betroffenen Bevölkerungsgruppen in Gabun. Durch seine Initiativen zur Aufklärung und Stärkung der lokalen Gesundheitsinfrastrukturen habe Ramharter entscheidend dazu beigetragen, die Lebensbedingungen der Menschen vor Ort zu verbessern.
„Ich freue mich sehr, dass unser Team für seine Arbeit ausgezeichnet wird,“ sagte Prof. Ramharter bei der Preisverleihung in Berlin. „In den betroffenen Gebieten sind oftmals mehr als 70% der erwachsenen Bevölkerung mit dem Augenwurm infiziert. Wenn dies die Bevölkerung von Berlin oder Paris beträfe, käme es wohl zu einem Aufschrei, um adäquate medizinische Versorgung zu entwickeln und zu ermöglichen. Wir müssen dringend mehr Aufmerksamkeit und Ressourcen auf die Bekämpfung dieser Krankheit lenken.“

Hintergrund
Der Memento Preis für vernachlässigte Krankheiten wurde 2014 von Ärzte ohne Grenzen e.V., Brot für die Welt, der BUKO Pharma-Kampagne und der DAHW Deutsche Lepra- und Tuberkulosehilfe e.V. ins Leben gerufen. Die Auszeichnung würdigt jährlich besonderes Engagement in der Bekämpfung von vernachlässigten Krankheiten und umfasst neben wissenschaftlichen Forschungsprojekten auch journalistische Initiativen, die kaum beachtete Gesundheitsbedürfnisse durch umfassende Berichterstattung sichtbar machen. Die Preise sind mit je 5.000 Euro dotiert.
Ansprechperson
Prof. Dr. Michael Ramharter
Klinische Forschung
Telefon : +49 40 285380-511
E-Mail : ramharter@bnitm.de
Julia Rauner
Presse- & Öffentlichkeitsarbeit
Telefon : +49 40 285380-264
E-Mail : presse@bnitm.de
Dr. Anna Hein
Presse- & Öffentlichkeitsarbeit
Telefon : +49 40 285380-269
E-Mail : presse@bnitm.de
Weiterführende Informationen